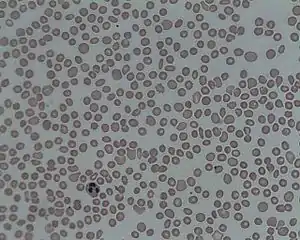

ترومبوسیتوپنی
ترومبوسیتوپنی (به انگلیسی: Thrombocytopenia) به اختلال در پلاکتهای خون یا ترومبوسیتها گفته میشود. این اختلال بیشتر به کاهش تعداد آنها به کمتر از ۵۰۰۰۰ در هر میکرولیتر خون، بازمیگردد.[1] تعداد پلاکتها بهطور طبیعی حدود ۱۵۰ هزار تا ۴۵۰ هزار عدد در هر میکرولیتر خون میباشد.[2] اختلاف تا دو درصد ارزش عددی از این بازه نمیتواند بیماری شمرده شود اما تعداد پلاکتهای زیر ۵۰۰۰۰ به عنوان یک اورژانس محسوب میشود.[3] و در تعداد زیر ۲۰۰۰۰ خطر مرگ ناشی از خونریزی خودبخودی و کشنده گوارشی و مغزی وجود دارد. معمولاً وجود اختلالات و نارساییها در هموستاز یا روند انعقاد خون، به صورت خونریزی زیرپوستی و کبودشدگی مخاطی بروز مییابد به ویژه اگر دلیل اختلال انعقاد خون کاهش تعداد پلاکتها یا عدم عملکرد صحیح پلاکتها باشد. این لکههای خونریزی زیرپوستی (و گاه زیر مخاطی) بر اساس اندازه به نامهای پتشی، پورپورا و اِکیموز نامگذاری میشوند.
| ترومبوسیتوپنی | |
|---|---|
![]() | |
| ترومبوسیتوپنی در خون زیر میکروسکوپ | |
| طبقهبندی و منابع بیرونی | |
| تخصص | خونشناسی |
| آیسیدی-۱۰ | D69.6, P61.0 |
| آیسیدی-9-CM | 287.3, 287.4, 287.5 |
| اُمیم | 188000 313900 |
| دادگان بیماریها | 27522 |
| مدلاین پلاس | 000586 |
| پیشنت پلاس | ترومبوسیتوپنی |
| سمپ | D013921 |
علامتها و نشانهها
این اختلال دارای علایم ویژه نیست و معمولأ در یک آزمایش ساده شمارش کامل خون مشخص میشود. گاهی بیماران مبتلا به ترومبوسیتوپنی از خونریزی بیرون از بدن مانند خوندماغ، خونریزی لثه و نیز خونریزی قاعدگی، گزارش دادهاند.[4][5]
علل ترومبوسیتوپنی
علل ترومبوسیتوپنی میتواند ارثی ویا اکتسابی باشد.[6]
کاهش در پلاکت
علل کاهش تولید
- نارسایی مغز استخوان یا ساپرسیون مغز استخوان یا ارتشاح مغز استخوان
- نقص و کمبود دهیدراسیون, کمبود ویتامین ب۱۲ یا اسید فولیک
- سرطان خون یا سندرم میلودیسپلاستیک ویا کمخونی آپلاستیک
- کمبود تولید ترومبوپویتین توسط کبد در نارسایی کبد
- سِپسی و عفونتهای ویروسی مانند ایدز
- سندروم ویسکوت آلدریچ، نشانگان آلپورت ویا الکلیسم مزمن
افزایش در پلاکت
علل افزایش مانند
درمان
درمان ترومبوسیتوپنی بسته به عامل بیماریزا است و درمانهای مختلف از تزریق پلاکت، پلاسمافرزیس، IVIg، کورتیکواستروئید، اسپلنکتومی، داروهای تضعیفکننده ایمنی مانند سیکلوفسفاماید و آزاتیوپرین و تعویض پلاسما وجود دارد.
جستارهای وابسته
منابع
- Deutschman, Clifford S.; Neligan, Patrick J. (2010). Evidence-based Practice of Critical Care. Elsevier Health Sciences. ISBN 1416054766. Retrieved 2015-04-30.
- "Platelet count: MedlinePlus Medical Encyclopedia". www.nlm.nih.gov. Retrieved 2015-05-01.
- "What Is Thrombocytopenia? - NHLBI, NIH". www.nhlbi.nih.gov. Retrieved 2015-05-01.
- BHATIA, M.P.S. "B.E. PROJECT ON PLATELET COUNT USING IMAGE PROCESSING TECHNIQUES" (PDF). BTP_Report. Archived from the original (PDF) on 5 December 2014. Retrieved 30 November 2014.
- Houghton, Andrew R.; Gray, David (2010-05-28). Chamberlain's Symptoms and Signs in Clinical Medicine 13th Edition, An Introduction to Medical Diagnosis. CRC Press. ISBN 9780340974254. Retrieved 2015-05-01.
- "What Causes Thrombocytopenia?". National Heart, Lung, and Blood Institute. Retrieved 4 December 2014.